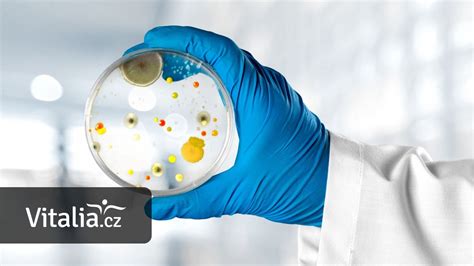
Schéma pôsobenia antibiotika

Amoksiklav 156.25/5 ml je liek, ktorý patrí do skupiny antibiotík a je určený na liečbu bakteriálnych infekcií u detí. Jeho účinok spočíva v usmrcovaní baktérií, ktoré spôsobujú ochorenia.
Liek obsahuje dve účinné látky: amoxicilín a kyselinu klavulánovú. Amoxicilín je súčasťou skupiny liečiv známych ako penicilíny, ktoré sa však za určitých okolností môžu stať neúčinnými. Kyselina klavulánová pôsobí ako ochranný faktor, ktorý bráni neúčinnosti amoxicilínu.
Amoksiklav 156.25/5 ml je predpisovaný dojčatám a deťom na liečbu rôznych typov infekcií:
- Infekcie stredného ucha a prinosových dutín.
- Infekcie dýchacích ciest.
- Infekcie močových ciest.
- Infekcie kože a mäkkých tkanív.
- Infekcie zubov.
- Infekcie kostí a kĺbov.
Dávkovanie a spôsob podania
1 ml suspenzie Amoksiklavu obsahuje 25 mg amoxicilínu (vo forme trihydrátu) a 6,25 mg kyseliny klavulánovej (vo forme klavulanu draselného). Odporúčané dávky sú udávané vo vzťahu k obsahu amoxicilínu/kyseliny klavulánovej.
Dospelí a deti s telesnou hmotnosťou ≥ 40 kg
Podáva sa 500 mg/125 mg pravidelne každých 8 hodín, čo zodpovedá 20 ml suspenzie.
Deti s telesnou hmotnosťou < 40 kg
Dávkovanie sa pohybuje od 20 mg/5 mg/kg/deň do 60 mg/15 mg/kg/deň, čo zodpovedá 0,8 ml suspenzie/kg/deň až 2,4 ml suspenzie/kg/deň. Dávka sa rozdelí do 3 dávok podávaných v pravidelných 8-hodinových intervaloch.
U veľmi malých detí, vrátane predčasne narodených detí v prvom týždni života, nesmie interval podávania prekročiť 2x denne.
Pacienti s poruchou funkcie obličiek
Dospelí a deti s telesnou hmotnosťou ≥ 40 kg:
- Pri klírense kreatinínu (CrCl) 10 - 30 ml/min: podáva sa 500 mg/125 mg 2x denne (20 ml suspenzie každých 12 hodín).
- Pri CrCl < 10 ml/min: podáva sa 500 mg/125 mg 1x denne (20 ml suspenzie každých 24 hodín).
- Počas hemodialýzy: podáva sa 500 mg/125 mg každých 24 hodín, plus 500 mg/125 mg počas dialýzy, s opakovaným podaním po jej ukončení.
Deti s telesnou hmotnosťou < 40 kg:
- Pri CrCl 10 - 30 ml/min: podáva sa 15 mg/3,75 mg/kg, t.j. 0,6 ml suspenzie/kg (maximálne 500 mg/125 mg, t.j. 20 ml suspenzie) každých 12 hodín.
- Pri CrCl < 10 ml/min: podáva sa 15 mg/3,75 mg/kg, t.j. 0,6 ml suspenzie/kg ako jednorazová denná dávka (maximálne 500 mg/125 mg, t.j. 20 ml suspenzie).
- Počas hemodialýzy: podáva sa 15 mg/3,75 mg/kg, t.j. 0,6 ml suspenzie/kg každých 24 hodín. Pred hemodialýzou sa má podať 15 mg/3,75 mg/kg. Po hemodialýze sa má podať 15 mg/3,75 mg/kg, aby sa obnovili hladiny liečiv v krvnom obehu.
Dĺžku liečby určí lekár na základe odpovede pacienta. Niektoré infekcie, napríklad osteomyelitída, si vyžadujú dlhšiu liečbu. Liečba nemá presiahnuť 14 dní bez jej prehodnotenia.
How to reconstitute co amoxiclav?
Príprava a použitie lieku
Pred použitím je potrebné skontrolovať, či je plomba pod viečkom neporušená. Liek sa v lekárni pred výdajom pacientovi spracováva riedením na suspenziu určenú na perorálne použitie (cez ústa).
Pred odobratím každej dávky je potrebné obsah fľaše dôkladne pretrepať. Na odmeranie presnej dávky slúži odmerka, ktorá je súčasťou balenia lieku.
Suspenzia sa podáva tesne pred jedlom alebo na začiatku jedla, aby sa minimalizovala možná gastrointestinálna intolerancia. Je potrebné dodržiavať pravidelné časové intervaly s minimálne 4-hodinovým odstupom. Nepodávajte 2 dávky v priebehu 1 hodiny.
Pripravená suspenzia sa uchováva v chladničke pri teplote 2-8 °C a je možné ju používať najviac 7 dní od prípravy.
Upozornenia a vedľajšie účinky
Počas tehotenstva sa liek nemá používať, pokiaľ lekár nerozhodne inak. Liek sa má použiť počas dojčenia len po prehodnotení pomeru prínos/riziko.
U pacientov s poruchou funkcie pečene sa má liek podávať opatrne a v pravidelných intervaloch sa má monitorovať funkcia pečene.
Ak sa objaví alergická reakcia, liečba amoxicilínom/kyselinou klavulánovou sa musí prerušiť a začať vhodná alternatívna liečba.
Počas užívania lieku sa môžu vyskytnúť nežiaduce účinky (alergické reakcie, závraty, kŕče), ktoré môžu ovplyvniť schopnosť viesť vozidlá a obsluhovať stroje.
Liek obsahuje aspartám (8,32 mg aspartámu v 5 ml perorálnej suspenzie), ktorý je zdrojom fenylalanínu. Môže byť škodlivý v prípade fenylketonúrie.
Je potrebné zabezpečiť pacientovi dostatočný prísun tekutín a pokoj na lôžku počas celej doby liečby.
Tak ako všetky lieky, aj Amoksiklav môže spôsobovať vedľajšie účinky, hoci sa neprejavia u každého. Zriedkavé vedľajšie účinky (postihujú menej ako 1 z 1000 osôb) zahŕňajú kožnú vyrážku, z ktorej sa môže vytvoriť pľuzgier a ktorá vyzerá ako malý terč (v strede tmavé bodky).

tags: #antibiotika #amoksiklav #156 #25 #5 #ml